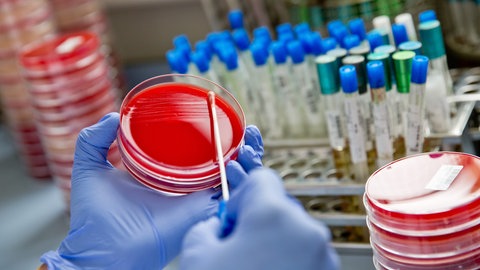
Eine Labormitarbeiterin verstreicht im Diagnostiklabor Untersuchungsmaterial mit einem Abstrichtupfer auf einer Bakterienkulturplatte. Antibiotikaresistenz: Was tun, wenn Antibiotika nicht mehr gegen Bakterien und Krankenhauskeime wirken? Prof. Peter Seeberger forscht an neuen Medikamenten, auch gegen Krebs und Malaria. Antibiotikaresistenz ist eine große Gefahr - in SWR1 Leute erzählt er von seiner Forschung an neuen Medikamenten und Impfstoffen.

Das Thema Krebs betrifft uns alle.
500.000 Menschen erkranken in Deutschland jedes Jahr neu an Krebs
Die Deutsche Krebshilfe informiert über Krebserkrankungen, betreibt Aufklärung zu Prävention, fördert Forschungsprojekte und macht mit ihren – teils prominenten – Botschaftern Öffentlichkeitsarbeit.
Nur ein aufgeklärter Patient wird auch am Erfolg seiner Behandlung mitwirken können.
Die Deutsche Krebshilfe gehört zu den wichtigsten privaten Geldgebern auf dem Gebiet der Krebsforschung. Gegründet wurde die Stiftung 1974 von der Ärztin Dr. Mildred Scheel, der Ehefrau des damaligen Bundespräsidenten Walter Scheel.
Krebs Früherkennung und bessere Versorgung krebskranker Menschen
1978, mit 22, fing der gelernte Industriekaufmann bei der Deutschen Krebshilfe an: Er gestaltete Förderprogramme, übernahm die Geschäftsführung, später den Vorstand. Seine Motivation: Sich für die Verbesserung der Versorgung krebskranker Menschen einzusetzen. Im Jahr 2016 erhielt Nettekoven dafür die Johann-Georg-Zimmermann-Medaille, eine der höchsten Auszeichnungen für Verdienste in der Krebsbekämpfung in Deutschland.
40 Prozent der Neuerkrankungen wären vermeidbar, würden wir uns alle gesundheitsbewusster verhalten – also nicht rauchen, wenig Alkohol, UV-Schutz beachten, Bewegung.
50 Jahre Deutsche Krebshilfe
Mit Gerd Nettekoven sprechen wir in SWR1 Leute über die Arbeit der Deutschen Krebshilfe, schauen auf die Meilensteine von 50 Jahren Geschichte und sprechen über die Bedeutung der Früherkennung von Krebserkrankungen.
Wir müssen Krebskrankheiten, da wo es möglich ist, vermeiden und nicht nur immer den kurativen Blick haben, also Krebskrankheiten zu behandeln.
* Im Dezember 2024 ist Gerd Nettekoven in den Stiftungsrat der Organisation gewechselt.